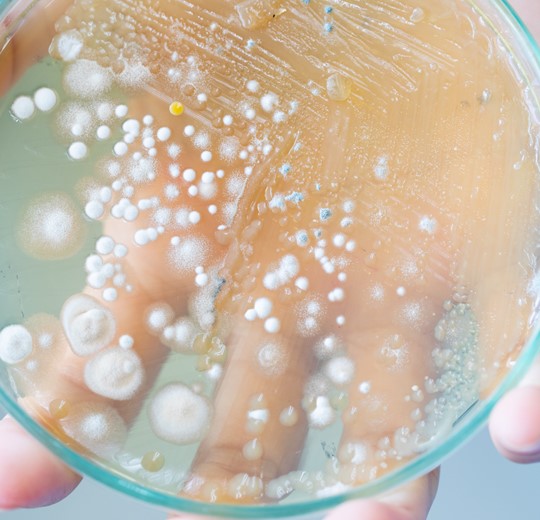

We use cookies to offer you the best experience on our site. You can find out more about the cookies we use or disable them in the Cookie settings

Tenray® ultrafine zinc oxide provides broadband antimicrobial boosting. Use of Tenray® helps to reduce the growth of gram+ and gram- bacteria, mold, fungi and yeasts when used in combination with EPA and BCR registered antimicrobials.
Tenray® ultrafine zinc oxide provides broadband antimicrobial boosting. Use of Tenray® helps to reduce the growth of gram+ and gram- bacteria, mold, fungi and yeasts when used in combination with EPA and BCR registered antimicrobials.

Tenray® zinc oxides protect against broadband UVA-UVB light when used in flexible and rigid transparent food packaging. Using Tenray® protects sensitive food elements such as fats, proteins and and vitamins resulting in a reduction of food waste.
Tenray® zinc oxides are food contact approved and non-migratory.
Tenray® zinc oxides protect against broadband UVA-UVB light when used in flexible and rigid transparent food packaging. Using Tenray® protects sensitive food elements such as fats, proteins and and vitamins resulting in a reduction of food waste.
Tenray® zinc oxides are food contact approved and non-migratory.

In a world evolving from a linear economy to a circular economy, plastic waste reduction is becoming a focus point. Longer durability and downgauging is a key requirement in agricultural and industrial films to reduce plastic waste streams.
Tenray® will provide long term durability in PE, PET, and PLA films.
In a world evolving from a linear economy to a circular economy, plastic waste reduction is becoming a focus point. Longer durability and downgauging is a key requirement in agricultural and industrial films to reduce plastic waste streams.
Tenray® will provide long term durability in PE, PET, and PLA films.

Odor control is required in textile applications to capture intensive odors of packaged food products and to reduce foul aromas that can occur from manufactured recycled plastics.
Tenray® ultrafine zinc oxides capture odors originating from sulphur compounds and is effective against odor-causing gram+ and gram- bacteria.
Odor control is required in textile applications to capture intensive odors of packaged food products and to reduce foul aromas that can occur from manufactured recycled plastics.
Tenray® ultrafine zinc oxides capture odors originating from sulphur compounds and is effective against odor-causing gram+ and gram- bacteria.

The Sweet Living Group is Evercare’s global exclusive distributor for Tenray® products for the textile fields. This includes yarn, fiber, finished cloth and laundry detergents for textiles. Their ecoZinc brand is powered by Tenray®.
Subscribe to our newsletter and receive the latest information about Evercare and our high quality ultrafine zinc oxides.
We use cookies to offer you the best experience on our site. You can find out more about the cookies we use or disable them in the Cookie settings